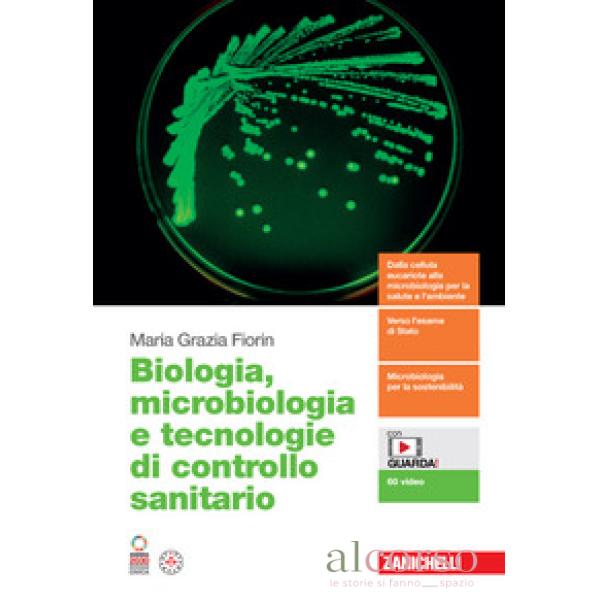

Call us
Free Support: 0438 22725
Elenco dei prodotti per la marca Zanichelli
QUANTO SIAMO CLASSICI. VERSIONI DI LATINO E DI...
Prezzo
38,90 €
Non disponibile
DIRITTO ED ECONOMIA TRA MONDO REALE E DIGITALE....
Prezzo
26,80 €
Disponibile subito
TESTI, FRASI, PAROLE. GRAMMATICA E LESSICO. PER...
Prezzo
27,40 €
Non disponibile
ARTELOGIA. IDEE PER IMPARARE 1. PER LE SCUOLE...
Prezzo
38,60 €
Non disponibile
MATEMATICA IN AZIONE VOL.A + B + FASCICOLO VOL. 1
Prezzo
30,00 €
Non disponibile